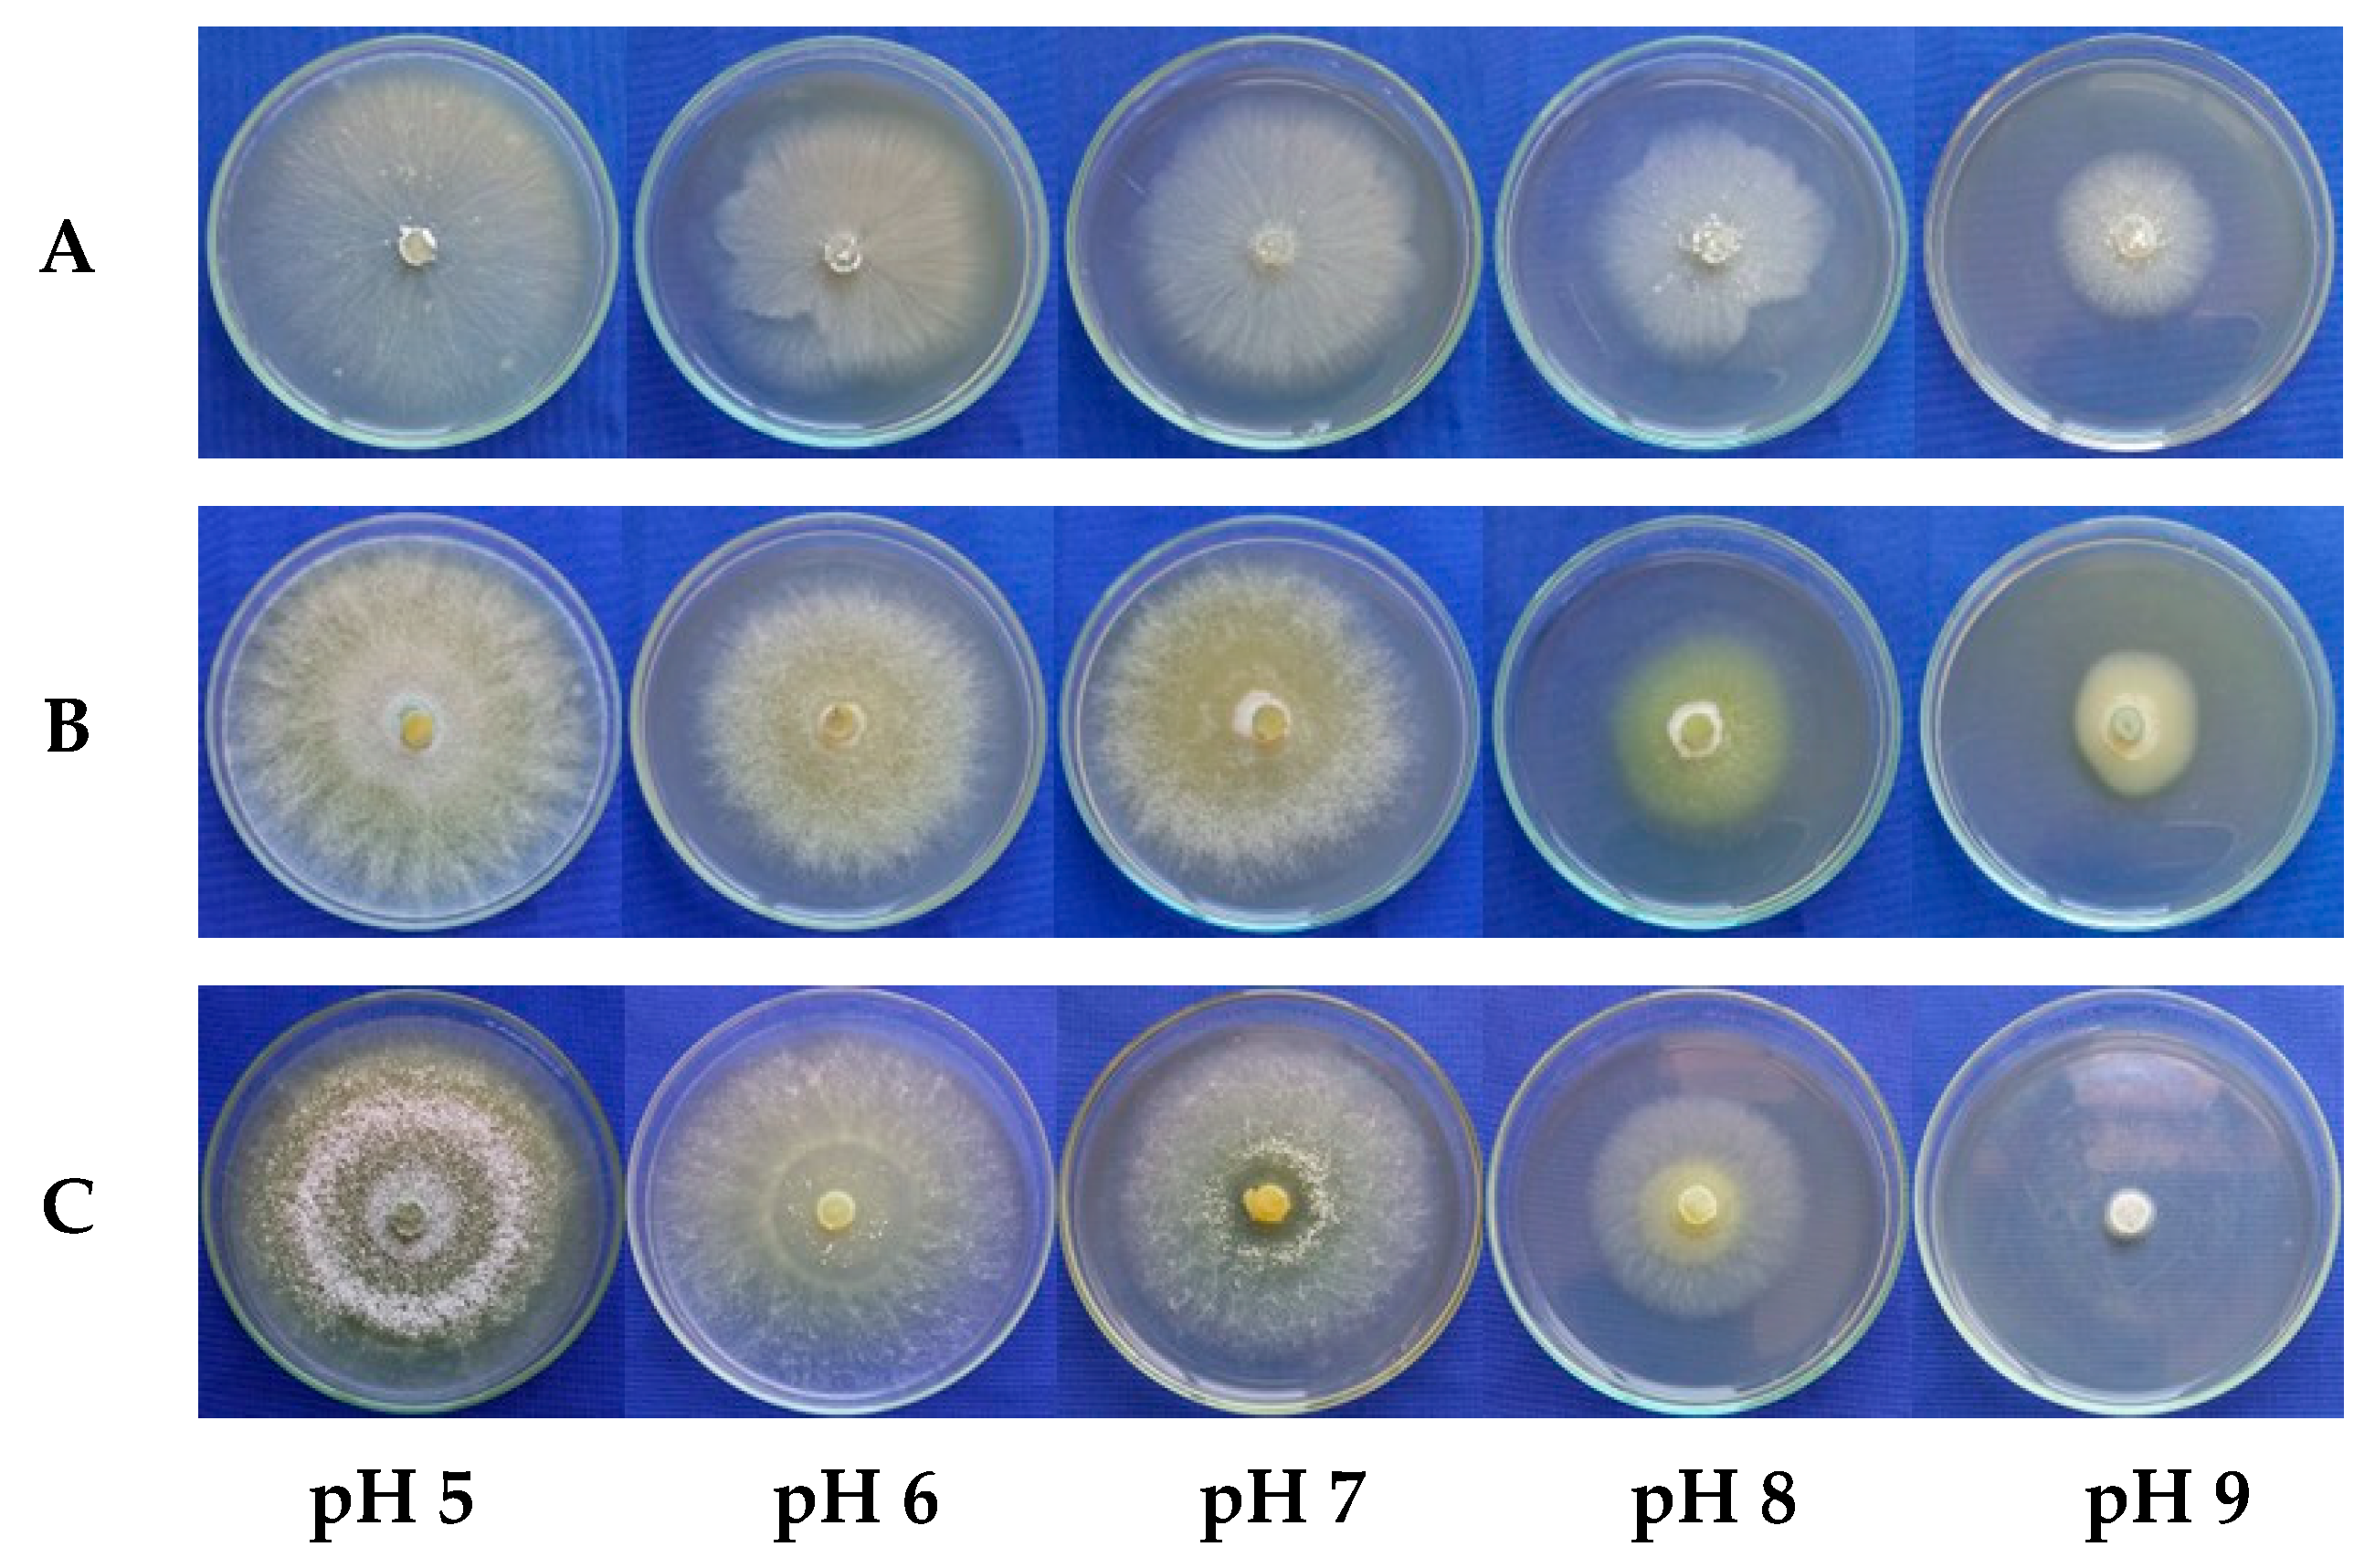
Microorganisms 13 01689 g005 Microorganisms 13 01689 g005

Adaptability and Sensitivity of Trichoderma spp. Isolates to Environmental Factors and Fungicides
Abstract
1. Introduction
2. Materials and Methods
2.1. Trichoderma spp. Isolates
2.2. Effect of Temperature, pH, and Salinity on the Mycelial Growth Rate of Trichoderma spp.
2.3. Sensitivity of Trichoderma spp. to Fungicides
2.4. Experimental Design and Data Analysis
3. Results
3.1. Effect of Temperature on the Mycelial Growth Rate of Trichoderma spp.
3.2. Effect of pH on the Mycelial Growth Rate of Trichoderma spp.
3.3. Effect of Salinity on the Mycelial Growth Rate of Trichoderma spp.
3.4. Sensitivity of Trichoderma spp. to Fungicides
4. Discussion
5. Conclusions
Author Contributions
Funding
Institutional Review Board Statement
Informed Consent Statement
Data Availability Statement
Acknowledgments
Conflicts of Interest
Abbreviations
| AzD | Azoxystrobin + Difenoconazole |
| BCAs | Biological control agents |
| BOD | Biochemical oxygen demand |
| Bos | Boscalid |
| CS | Concentrated suspension |
| Dif | Difenoconazole |
| EC | Emulsifiable concentrate |
| Flu | Fludioxonil |
| IDM | Integrated disease management |
| MeP | Metiram + Pyraclostrobin |
| MGR | Mycelial growth rate |
| NaCl | Sodium chloride |
| NaOH | Sodium hydroxide |
| OT | Optimal temperature |
| PDA | Potato dextrose agar |
| WG | Water dispersible granule |
References
- Khirallah, W.; Mouden, N.; Selmaoui, K.; Achbani, E.H.; Benkirane, R.; Touhami, A.O.; Douira, A. Compatibility of Trichoderma spp. with some fungicides under in vitro conditions. Int. J. Recent Sci. Res. 2016, 7, 9060–9067. [Google Scholar]
- Oliveira, L.L.B.; Moraes, J.G.L.; Silva, C.F.B.; Sousa, A.B.O.; Beleza, N.M.V.; Jacinto Júnior, S.G. Influência da temperatura e radiação ultravioleta no desenvolvimento de isolados de Trichoderma spp. Rev. Bras. Meteorol. 2019, 34, 423–430. [Google Scholar] [CrossRef]
- Bettiol, W.; Morandi, M.A.B. Biocontrole de Doenças de Plantas: Usos e Perspectivas; Embrapa Meio Ambiente: Jaguariúna, Brazil, 2009; 341p. [Google Scholar]
- Gams, W.; Bisset, J.I.T.G. Morphology and identification of Trichoderma. In Trichoderma and Gliocladium: Basic Biology, Taxonomy and Genetics; Kubicek, C.P., Harman, G.E., Eds.; Taylor & Francis Ltd.: London, UK, 1998; pp. 3–31. [Google Scholar]
- Nascimento, V.C.; Rodrigues-Santos, K.C.; Carvalho-Alencar, K.L.; Castro, M.B.; Kruger, R.H.; Lopes, F.A.C. Trichoderma: Biological control efficiency and perspectives for the Brazilian Midwest states and Tocantins. Braz. J. Biol. 2022, 82, e260161. [Google Scholar] [CrossRef] [PubMed]
- Kubiak, A.; Wolna-Maruwka, A.; Pilarska, A.A.; Niewiadomska, A.; Piotrowska-Cyplik, A. Fungi of the Trichoderma genus: Future perspectives of benefits in sustainable agriculture. Appl. Sci. 2023, 13, 6434. [Google Scholar] [CrossRef]
- Lucon, M.M.C. Trichoderma no Controle de Doenças de Plantas Causadas por Patógenos de Solo. Comun. Técnico Inst. Biol. 2008, 77. Available online: http://www.biologico.agricultura.sp.gov.br/publicacoes/comunicados-documentos-tecnicos/comunicados-tecnicos/trichoderma-no-controle-de-doencas-de-plantas-causadas-por-patogenos-de-solo (accessed on 21 January 2025).
- Woo, S.L.; Ruocco, M.; Vinale, F.; Nigro, M.; Marra, R.; Lombardi, N.; Pascale, A.; Lanzuise, S.; Manganiello, G.; Lorito, M. Trichoderma-Based Products and Their Widespread Use in Agriculture. Open Mycol. J. 2014, 8, 71–126. [Google Scholar] [CrossRef]
- Thambugala, K.M.; Daranagama, D.A.; Phillips, A.J.L.; Kannangara, S.D.; Promputtha, I. Fungi vs. Fungi in Biocontrol: An Overview of Fungal Antagonists Applied against Fungal Plant Pathogens. Front. Cell. Infect. Microbiol. 2020, 10, e604923. [Google Scholar] [CrossRef] [PubMed]
- Tyśkiewicz, R.; Nowak, A.; Ozimek, E.; Jaroszuk-Ściseł, J. Trichoderma: The Current Status of Its Application in Agriculture for the Biocontrol of Fungal Phytopathogens and Stimulation of Plant Growth. Int. J. Mol. Sci. 2022, 23, 2329. [Google Scholar] [CrossRef] [PubMed]
- Abbey, L.; Abbey, J.; Leke-Aladekoba, A.; Iheshiulo, E.M.A.; Ijenyo, M. Biopesticides and biofertilizers: Types, production, benefits, and utilization. In Byproducts from Agriculture and Fisheries: Adding Value for Food, Feed, Pharma, and Fuels; Simpson, B.K., Aryee, A.N.A., Toldrá, F., Eds.; John Wiley & Sons Ltd.: Hoboken, NJ, USA, 2020; pp. 479–500. [Google Scholar]
- Kumar, J.; Ramlal, A.; Mallick, D.; Mishra, V. An overview of some biopesticides and their importance in plant protection for commercial acceptance. Plants 2021, 10, 1185. [Google Scholar] [CrossRef] [PubMed]
- Pertot, I.; Puopolo, G.; Giovannini, O.; Angeli, D.; Sicher, C.; Perazzolli, M. Advantages and limitations involved in the use of microbial biofungicides for the control of root and foliar phytopathogens of fruit crops. Italus Hortus 2016, 23, 3–12. [Google Scholar]
- Muhammad, M.; Wahab, R.A.; Huyop, F.; Rusli, M.H.; Yaacob, S.N.S.; Teo, H.L. An overview of the potential role of microbial metabolites as greener fungicides for future sustainable plant diseases management. J. Crop Prot. 2022, 11, 1–27. [Google Scholar]
- Mukhopadhyay, R.; Kumar, D. Trichoderma: A Beneficial Antifungal Agent and Insights into Its Mechanism of Biocontrol Potential. Egypt. J. Biol. Pest Control 2020, 30, e133. [Google Scholar] [CrossRef]
- Petrisor, C.; Paica, A.; Constantinescu, F. Influence of Abiotic Factors on In Vitro Growth of Trichoderma Strains. Proc. Rom. Acad. Ser. B 2016, 18, 11–14. [Google Scholar]
- Zehra, A.; Dubey, M.K.; Meena, M.; Upadhyay, R.S. Effect of Different Environmental Conditions on Growth and Sporulation of Some Trichoderma Species. J. Environ. Biol. 2017, 38, 197–203. [Google Scholar] [CrossRef]
- Onilude, A.A.; Seyi-Amole, D.O. Mycelia Growth and Spore Yield of Trichoderma harzianum in Batch and Fed-Batch Cultures: Influence of pH and Temperature. Int. J. Curr. Microbiol. Appl. Sci. 2018, 7, 627–635. [Google Scholar] [CrossRef][Green Version]
- Adnan, M.; Islam, W.; Shabbir, A.; Khan, K.A.; Ghramh, H.A.; Huang, Z.; Lu, G.D. Plant Defense against Fungal Pathogens by Antagonistic Fungi with Trichoderma in Focus. Microb. Pathog. 2019, 129, 7–18. [Google Scholar] [CrossRef] [PubMed]
- Moreno-Mateos, M.A.; Delgado-Jarana, J.; Codon, A.C.; Benítez, T. pH and Pac1 Control Development and Antifungal Activity in Trichoderma harzianum. Fungal Genet. Biol. 2007, 44, 1355–1367. [Google Scholar] [CrossRef] [PubMed]
- Louzada, G.A.S.; Carvalho, D.D.C.; Mello, S.C.M.; Lobo Júnior, M.; Martins, I.; Braúna, L.M. Antagonist Potential of Trichoderma spp. from Distinct Agricultural Ecosystems against Sclerotinia sclerotiorum and Fusarium solani. Biota Neotrop. 2009, 9, 145–149. [Google Scholar] [CrossRef]
- Andrés, P.A.; Alejandra, P.M.; Benedicto, M.C.; Nahuel, R.I.; Clara, B.M. A comparative study of different strains of Trichoderma under different conditions of temperature and pH for the control of Rhizoctonia solani. Agric. Sci. 2022, 13, 702–714. [Google Scholar] [CrossRef]
- Chahdi, A.O.; Chliyeh, M.; Mouria, B.; Dahmani, J.; Touhami, A.O.; Benkirane, R.; Achbani, E.H.; Douira, A. In vitro and in vivo effect of salinity on the antagonist potential of Trichoderma harzianum and sensitivity of tomato to Verticillium wilt. Int. J. Recent Sci. Res. 2014, 5, 780–791. [Google Scholar]
- Liu, Z.; Xu, N.; Pang, Q.; Khan, R.A.A.; Xu, Q.; Wu, C.; Liu, T. A salt-tolerant strain of Trichoderma longibrachiatum HL167 is effective in alleviating salt stress, promoting plant growth, and managing Fusarium wilt disease in cowpea. J. Fungi 2023, 9, 304. [Google Scholar] [CrossRef] [PubMed]
- Branco, J.S.; Cardoso, M.M.; Venturoso, L.R.; Venturoso, L.A.C. Compatibilidade de Trichoderma com fungicidas utilizados no tratamento de sementes de soja. Rev. Observ. Econ. Lat.-Am. 2025, 23, 1–16. [Google Scholar] [CrossRef]
- Joseph, L.A.; Sousa, K.Â.O.; Chagas Júnior, A.F.; Luc, F. Compatibility of fungicides with Trichoderma asperelloides and Azospirillum brasilense. Scient. Agrar. Paran. 2022, 21, 30–35. [Google Scholar] [CrossRef]
- Poudel, S.; Khanal, P.; Bigyan, K.C.; Pokharel, S.; Gauli, S. Biological Control of Fungal Phytopathogens with Trichoderma harzianum and Its Fungicidal Compatibility. Int. J. Appl. Biol. 2023, 7, 47–58. [Google Scholar] [CrossRef]
- Degani, O.; Chen, A.; Dimant, E.; Gordani, A.; Malul, T.; Rabinovitz, O. Integrated Management of the Cotton Charcoal Rot Disease Using Biological Agents and Chemical Pesticides. J. Fungi 2024, 10, 250. [Google Scholar] [CrossRef] [PubMed]
- Cavalcante, A.L.A.; Negreiros, A.M.P.; Tavares, M.B.; Barreto, E.S.; Armengol, J.; Sales Júnior, R. Characterization of five new Monosporascus species: Adaptation to environmental factors, pathogenicity to cucurbits and sensitivity to fungicides. J. Fungi 2020, 6, 169. [Google Scholar] [CrossRef] [PubMed]
- Silva, F.A.Z.; Azevedo, C.A.V. The Assistat Software Version 7.7 and its use in the analysis of experimental data. Afr. J. Agric. Res. 2016, 11, 3733–3740. [Google Scholar] [CrossRef]
- Domingues, M.V.P.F.; Moura, K.E.; Salomão, D.; Elias, L.M.; Patricio, F.R.A. Effect of Temperature on Mycelial Growth of Trichoderma, Sclerotinia minor and S. sclerotiorum, as Well as on Mycoparasitism. Summa Phytopathol. 2016, 42, 222–227. [Google Scholar] [CrossRef]
- Pires, T.G.; Negretti, R.R.D.; Nicolodi, M.I. Effect of Temperature on the Ability of Trichoderma harzianum to Parasitize Sclerotia of Sclerotinia sclerotiorum. Desarro. Local Sosten. 2023, 16, 3168–3176. [Google Scholar] [CrossRef]
- Alves, F.R.; Campos, V.P. Effects of Temperature on the Activity of Fungi in the Biological Control of Meloidogyne javanica and Meloidogyne incognita Race 3. Ciênc. Agrotecnol. 2003, 27, 91–97. [Google Scholar] [CrossRef]
- Guimarães, G.R.; Ferreira, D.S.; Galvão, C.S.; Mello, S.C.M.; Carvalho, D.D.C. Action of Volatile and Non-Volatile Metabolites of Trichoderma harzianum on the Growth of Cladosporium herbarum. Pesqui. Agropecu. Pernambucana 2016, 21, 7–11. [Google Scholar] [CrossRef]
- Lima, J.R.d.S.; Souza, R.M.S.; Santos, E.S.; Souza, E.S.; Oliveira, J.E.d.S.; Medeiros, É.V.; Pessoa, L.G.M.; Antonino, A.C.D.; Hammecker, C. Impacts of land-use changes on soil respiration in the semi-arid region of Brazil. Rev. Bras. Ciênc. Solo 2020, 44, e0200092. [Google Scholar] [CrossRef]
- Zhang, C.; Wang, W.; Hu, Y.; Peng, Z.; Ren, S.; Xue, M.; Liu, Z.; Hou, J.; Xing, M.; Liu, T. A Novel Salt-Tolerant Strain Trichoderma atroviride HN082102.1 Isolated from Marine Habitat Alleviates Salt Stress and Diminishes Cucumber Root Rot Caused by Fusarium oxysporum. BMC Microbiol. 2024, 22, e67. [Google Scholar] [CrossRef] [PubMed]
- Santoyo, G.; Orozco-Mosqueda, M.d.C.; Afridi, M.S.; Mitra, D.; Valencia-Cantero, E.; Macías-Rodríguez, L. Trichoderma and Bacillus Multifunctional Allies for Plant Growth and Health in Saline Soils: Recent Advances and Future Challenges. Front. Microbiol. 2024, 15, e1423980. [Google Scholar] [CrossRef] [PubMed]
- Oljira, A.M.; Hussain, T.; Waghmode, T.R.; Zhao, H.; Sun, H.; Liu, X.; Wang, X.; Liu, B. Trichoderma Enhances Net Photosynthesis, Water Use Efficiency, and Growth of Wheat (Triticum aestivum L.) under Salt Stress. Microorganisms 2020, 8, 1565. [Google Scholar] [CrossRef] [PubMed]
- Boamah, S.; Zhang, S.; Xu, B.; Li, T.; Calderón-Urrea, A.; John Tiika, R. Trichoderma longibrachiatum TG1 Increases Endogenous Salicylic Acid Content and Antioxidants Activity in Wheat Seedlings under Salinity Stress. PeerJ 2022, 10, e12923. [Google Scholar] [CrossRef] [PubMed]
- Widmer, T.L. Compatibility of Trichoderma asperellum Isolates to Selected Soil Fungicides. Crop Prot. 2019, 120, 91–96. [Google Scholar] [CrossRef]

| Isolate Code | Trichoderma Species | Product | Formulation 1 | Company |
|---|---|---|---|---|
| URM-5911 | T. asperellum | Quality® WG | WG | Lallemand Soluções Biológicas Ltd., Piracicaba, Brazil |
| TRA-0048 | T. asperellum | TrichobiolMax | CS | Biofungi Controle Biológico, Eunápolis, Brazil |
| TRL-0102 | T. longibrachiatum | TrichonemateMax | CS | Biofungi Controle Biológico, Eunápolis, Brazil |
Disclaimer/Publisher’s Note: The statements, opinions and data contained in all publications are solely those of the individual author(s) and contributor(s) and not of MDPI and/or the editor(s). MDPI and/or the editor(s) disclaim responsibility for any injury to people or property resulting from any ideas, methods, instructions or products referred to in the content. |
© 2025 by the authors. Licensee MDPI, Basel, Switzerland. This article is an open access article distributed under the terms and conditions of the Creative Commons Attribution (CC BY) license (https://creativecommons.org/licenses/by/4.0/).
Share and Cite
Cavalcante, A.L.A.; Negreiros, A.M.P.; Melo, N.J.d.A.; Santos, F.J.Q.; Soares Silva, C.S.A.; Pinto, P.S.L.; Khan, S.; Sales, I.M.M.; Sales Júnior, R. Adaptability and Sensitivity of Trichoderma spp. Isolates to Environmental Factors and Fungicides. Microorganisms 2025, 13, 1689. https://doi.org/10.3390/microorganisms13071689
Cavalcante ALA, Negreiros AMP, Melo NJdA, Santos FJQ, Soares Silva CSA, Pinto PSL, Khan S, Sales IMM, Sales Júnior R. Adaptability and Sensitivity of Trichoderma spp. Isolates to Environmental Factors and Fungicides. Microorganisms. 2025; 13(7):1689. https://doi.org/10.3390/microorganisms13071689
Chicago/Turabian StyleCavalcante, Allinny Luzia Alves, Andréia Mitsa Paiva Negreiros, Naama Jéssica de Assis Melo, Fernanda Jéssica Queiroz Santos, Carla Sonale Azevêdo Soares Silva, Pedro Sidarque Lima Pinto, Sabir Khan, Inês Maria Mendes Sales, and Rui Sales Júnior. 2025. "Adaptability and Sensitivity of Trichoderma spp. Isolates to Environmental Factors and Fungicides" Microorganisms 13, no. 7: 1689. https://doi.org/10.3390/microorganisms13071689
APA StyleCavalcante, A. L. A., Negreiros, A. M. P., Melo, N. J. d. A., Santos, F. J. Q., Soares Silva, C. S. A., Pinto, P. S. L., Khan, S., Sales, I. M. M., & Sales Júnior, R. (2025). Adaptability and Sensitivity of Trichoderma spp. Isolates to Environmental Factors and Fungicides. Microorganisms, 13(7), 1689. https://doi.org/10.3390/microorganisms13071689

